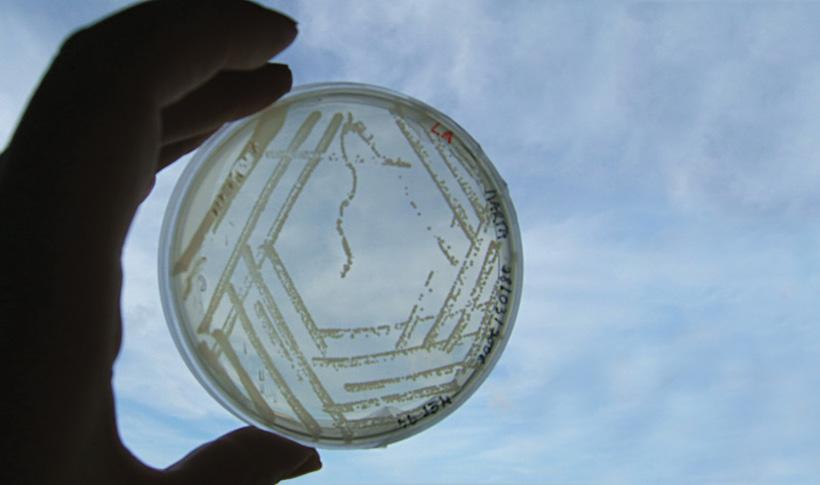

Message from the Organizing Committee The Schedule THE LABs The Institute
03 04 05 08 09 10 11 12 13
The Town of Oeiras The Social Program The Facilities The Registration The Organizing Committee
Message from the Organizing Committee
Dear colleague,

It is with great pleasure that ANEM/PorMSIC and the Organizing Committee introduce the first Science Summerschool specifically designed for Medical Students ever held in Portugal, taking place between the 19th and the 24th of July in Oeiras, Portugal.
Too large a number of students complete Medical School without significant contact with research. Research not only exposes medical students to scientific methodology and academic writing, but also encourages multi-tasking, communication, and critical analysis of the scientific literature - valuable skills that will serve us well in our future medical carriers.
Common barriers including time constraints, difficulty finding mentors, and abscence of training in basic research methodology are present in our country, as well as in many others across the scientific world.
To begin addressing these barriers, while at the same time enjoying the magnificent landscapes of the Natural Reserve of the Tagus river mouth and the beautiful beaches of Cascais, Estoril and Oeiras, ANEM/PorMSIC partnered with ITQB (Instituto de Tecnologia Química Biológica), a Research Institute where no less than 400 researchers dedicate their lives to scientific research and postgraduate training in chemistry, life sciences and associated technologies, while also serving the community and performing university extension activities for the promotion of science and technology.
Promoting Medical Student involvement and research productivity is, therefore, one of the main goals of ANEM/PorMSIC, finally brought to life in this Scientific Summerschool. We hope you enjoy this unique opportunity for personal growth and development as much as we enjoyed preparing it for you.
Warm regards, Ana Coimbra President of the Organizing Committee
The Schedule
We carefully planned the five days in order to provide both enough time for the development of practical skills and integration in the routine work of selected research groups, as well as some time to come together and explore important issues in the world of scientific production with those who are already in it.
During the social program, we will offer you the opportunity to get to know the capital city of Portugal - Lisbon - its culture and history, and the town of Oeiras, taking part in a wide range of outdoor activities in its atlantic landscapes.
Below, you may find the general agenda for the Science Summerschool.
09h30 - 10h00
10h00 - 10h30
10h30 - 11h00
11h00 - 11h30
11h30 - 12h00
12h00 -12h30
12h30 - 13h00
13h00 - 13h30
13h30 - 14h00
14h00 -14h30
14h30 -15h00
15h00 - 15h30
15h30 - 16h00
16h00 - 16h30
16h30 - 17h00
17h00 - 17h30
17h30 -18h00
18h00 -18h30
18h30 - 19h00
19h00 - 19h30
19h30 - 20h00
20h00 - 20h30
20h30 -21h00
21h00 -21h30
21h30 - 22h00
22h00 - 22h30
22h30 -23h00
23h00 -23h30
Su NDAy, J u Ly 19T h M ONDAy, J u Ly 20T h Tu ESDAy, J u Ly 21ST W EDNESDAy, J u Ly 22ND Thu RSDAy, J u Ly 23RD F RIDAy, J u Ly 24T h ArrivAl dAy Welcome to itQB lAB Work lAB Work lAB Work depArture dAy
Ch EC k- O u T
O PENIN g SESSION L AB
I NTROD u CIN g RESEARC h LABS
Lu NC h
ITQB O PEN L ABS R O u ND TABLE
L AB
Ch EC k- IN
kE y NOTE SPEA k ER
M OTI vATION Fu NDIN g Pu BLICATION T RANSLATION
D
INNER
S OCIAL PRO g RAM
The Labs
Each participant will have to choose one Research group in which he will be integrated for the five days of the Summerschool. There are 16 Research groups with 22 spots available. get to know them below, and how difficult the choice will be!
Biomolecular diagnostics


This multidisciplinary research team is committed to develop new biomolecular tools, such as nanoparticles (CdSe@ZnS quantum dots) and biosensors, for practical applications like disease diagnostic and bioprocess monitoring.

microbial development
Bacterial spores are encased in a protein shield (or coat) that confers resistance against noxious chemicals and predation, protects the underlying cortex peptidoglycan layer from the action of lytic enzymes, and is a key sensor of the environment. The spore surface proteins are synthesized in the mother cell, one of the two compartments of the sporulating cell. The Microbial Development group studies development in the model organism Bacillus subtilis, which involves metamorphosis of the rod-shaped vegetative cell into a dormant, highly resistant spore.
Nutraceuticals and delivery
This laboratory uses clean technologies for isolation and development of health promoting products. high pressure methodologies are applied for the extraction of bioactive compounds and preparation of new delivery systems. As the name suggests, this laboratory encompass two different areas of research: Nutraceuticals , related with extraction of natural bioactive ingredients and formulation of functional products with health benefits, and Controlled Delivery associated with the development of adequate systems to overcome barriers to drug’s usefulness, involving particle formation (micro and nano-scale), and incorporation of the active principles in biocompatible and biodegradable matrixes.
organic Synthesis

Natural product syntheses are a great challenge since the product gross structure and stereochemistry are rigorously defined. Any synthesis is a test of the viability of the strategy and of the compatibility of the reagents. The organic synthesis group is dedicated to the synthesis of compounds which have a relatively complex three-dimensional structure and which may not necessarily be related to the gross structure.
protein modeling
The Protein Modeling Laboratory works on molecular modeling of proteins using physical methods. Its areas of work range from basic research in modeling methodologies to applications with biotechnological and biomedical interest.
Genomics and Stress laboratory

The genomics and stress laboratory works in the mechanisms involved in homeostasis control when yeast cells are exposed to different environmental cues. The function of yap transcription factors in stress response is investigated.
Applied and environmental micology
The Applied and Environmental Mycology group aims to enlarge filamentous fungi biotechnological potential. Research ranges from fundamental studies on fungal biology to applications in bioremediation and biocatalysis, also highlighting ionic liquids higher interest.

Bacterial energy metabolism
The Bacterial Energy Metabolism laboratory investigates the molecular basis of metabolic pathways for energy production, in microorganisms that are biotechnologically and environmentally important.
Bacterial evolution and molecular epidemiology
The Laboratory of Bacterial Evolution and Molecular Epidemiology aims to understand the molecular basis of bacterial evolution with focus on the evolution of antimicrobial resistance determinants and antimicrobial resistant clones in coagulase-negative staphylococci (CoNS).
Bacterial cell Biology
In the Bacterial Cell Biology laboratory we use the gram positive pathogen Staphylococcus aureus to study the mechanisms of cell division and of antibiotic resistance to cell wall targeting antibiotics.
cell Signaling in drosophila
We use Drosophila as a model system to study the molecular and cellular signaling mechanisms involved in the degeneration of the photoreceptors, the cells that sense light in the visual system.


molecular microbiology of Human pathogens
In our group we are studying how human interventions, such as the use of vaccines and antibiotics, impact on the nasopharyngeal ecosystem, a rich niche frequently inhabited by potentially pathogenic bacteria such as Streptococcus pneumoniae.
coordination and Supramolecular chemistry
The Coordination and Supramolecular Chemistry group designs and synthesizes new molecules for the selective uptake of anions, neutral molecules or metal ions for environmental and medical applications.

Bioorganic chemitry
Chemistry is the interface of organic chemistry and biology. Our research uses the principles and techniques of organic chemistry in attempting to solve problems of relevance to biology. We can design synthetic derivatives of natural products, that improve on nature.


Bacterial cell Surfaces and pathogenesis
This group studies how bacteria synthesize a major component of their cell surface, the peptidoglycan, while simultaneously preventing the infected host from detecting this inflammatory macromolecule that can trigger an innate immune response.

The Institute
The ITQB is an interdisciplinary research and advanced training institute of uNL located in the Town of Oeiras, just outside Lisbon.

ITQB has a strong expertise in Molecular Biosciences, covered by four broad scientific disciplines: Cellular and Molecular Biology, Molecular and Structural Biology, Biotechnology and Systems Biology, and Chemical Biology. These scientific disciplines drive ITQB research, contributing to strategic Societal Challenges focused on the well-being of human societies (Molecular Basis of health and Disease) and on the environment (Biological Resources and Sustainable Development).
The current 56 Laboratories are organized into five Research Divisions - Chemistry, Biological Chemistry, Biology, Plant Sciences, and Technology. In many cases the allocation of a particular Laboratory to a Division is an organizational convenience and collaboration between Divisions is strongly encouraged.

The diversity of expertise present at ITQB contributes to the multidisciplinary atmosphere that makes this Institute unique in the country. ITQB’s highly multidisciplinary nature makes it a leading centre for advanced training of researchers in Portugal.
ITQB is actively involved in bringing its research closer to the society at large, in particular in the Oeiras community. Many of ITQB’s initiatives target young students – the future Portuguese scientists – and include visits from high schools, summer training and science displays.
53 RESEARCh gROuPS
FAct S AN d Fi G ure S 115 PuBLICATIONS WITh INTERNATIONAL TEAMS 14.6 M€ OvERALL BuDgET 109 RESEARCh PROJECTS 291 RESEARCh ARTICLES
417 RESEARChERS 186 PhD hOLDERS 38 PhD ThESES
“It is at present one of the broadest in scientific expertise, spanning from Chemistry to Medicine, i.e., from “the molecule to the clinical”
The Town of Oeiras
Oeiras is a town in the western part of the Lisbon Metropolitan Area, in continental Portugal. The region is a technology and service incubator with the purposeful creation of many science, technology, research institutes and business parks, and is occupied by several facilities, including private television networks, many large multinational and technology companies and other important nacional enterprises, as well as several secutiry and governmental institutions.
The mild climate, access to water, quality of its soils and geographically privileged location at the mouth of the Tagus River attracted early settlement to this region, dating back to 1208, when the area was colonized by Christian tribes from the northern Portugal, moving south into warmer agricultural lands.
Oeiras offers a range of points of interest, from the Fábrica da Pólvora (gunpowder Factory), a recovered arms factory used for leisure and cultural purposes; the Poets Park, a green space with statues of Portuguese poets and writers; and the historical Palace of the Royal Estate in Caxias (that dates from the 18th century and surrounded by gardens).
Leisure and sports facilities include the sports complex of Jamor, the Maritime Walk (a seaside promenade that links Algés to the Torre beach) or the modern marina at Oeiras, prepared to welcome ships, in addition to other local parks and green-spaces. Many of the former town centres have been recovered, displaying monuments and tourist-oriented venues for leisure, cultural, gastronomic and social events.

The Social Program
Oeiras is a town evolving rapidly and it offers many sites of interest and different activities through day and night. During the stay, the participants will have the opportunity to explore the city, enjoy the beautiful Tagus beaches and the many historical landmarks.

Every night you will have the opportunity to participate in a very special social program, including a night tour in Lisbon. There are endless party spots, bars and terraces, castles, monuments and gastronomic atractions.

The Facilities
The accommodation will be provided in the INATEL Oeiras. Just a stone’s throw from the capital, overlooking the Tagus estuary and with a view of Bugio and Mar da Palha, INATEL Oeiras offers the possibility of combining a calm and restful holiday with easy access to nearby Lisbon and its cosmopolitan lifestyle.
Because of its location, INATEL Oeiras offers an excellent opportunity and good conditions for reconciling work and leisure in a pleasant and peaceful environment.

The hotel has 138 totally equipped apartments and individual parking space. Two bars with outdoor patios, Wi-Fi, restaurant with a panoramic view, meeting room, playground and swimming pool.

The Registration
To register, you simply have to fill in the registration form in ANEM’s website:
ANem.pt
Registration will be open in three phases. Please refer to the Rules for further explanation. The registration fee covers the scientific program, accomodation and lunch every day:
Early fee: 195€ | Late fee: 220€
early registration will open on the 6th of may and close on the 13th. During this period, you will be able to choose which Research group you want the most for your summerschool. After registration and if you are accepted, you will be sent the final confirmation. When you receive it, you will have five days to proceed with the payment by bank transfer and to send the bank statement to administracao@anem.pt. your registration will be cancelled after five days if you fail to do so.
late registration will occur on the same terms, from the 19th of may until the 24th of may. A third registration period may be opened according to the regulations.
If you have any issues regarding this topic, please e-mail the OC and we will clarify your doubts.
B AN k iNForm Atio N NAME ANem ADDRESS ANem-AeFmup Al AmedA proF. HerNâNi moNterio HSJ piSo 01 4200-319 porto, portuGAl NIB 0035 0651 0051 5859530 17 IBAN pt50 0035 0651 00515859530 17 BIC SWIFT cGdiptpl
The Organizing Committee
Ana Coimbra President of the Organizing Committee administracao@anem.pt




 Lara Mendes
Joana Maia
Bernardo Marques da Silva
Pilar Burillo Simões
Lara Mendes
Joana Maia
Bernardo Marques da Silva
Pilar Burillo Simões

Lara Mendes
Joana Maia
Bernardo Marques da Silva
Pilar Burillo Simões
Lara Mendes
Joana Maia
Bernardo Marques da Silva
Pilar Burillo Simões